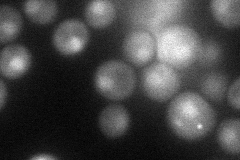
YGR288W
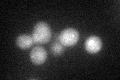
YGR288W

View description
MAL-activator protein, part of complex locus MAL1; nonfunctional in genomic reference strain S288C
Localization:
Intensity:
Fold change:
Significance:
-
C’ GFP library in SD

below threshold17.1 -
N' NOP1pr-GFP in SD

cytosol,nucleus47.9293 -
N' TEF2pr-mCherry in SD
nucleus36.9314 -
N' NATIVEpr-GFP in SD

below threshold20.1073 -
N' TEF2pr-VC and Cyto-VN in SD

cytosol34.5274 -
C’ GFP library in SD+DTT
cytosol22.821.33No -
C’ GFP library in SD+H2O2

cytosol19.281.12No -
C’ GFP library in Starvation Media

cytosol19.061.11No -
C’ GFP library on the background of Pup2-DaMP

below threshold -
C’ GFP library on the background of CCT mutant

below threshold18.5591.085No
